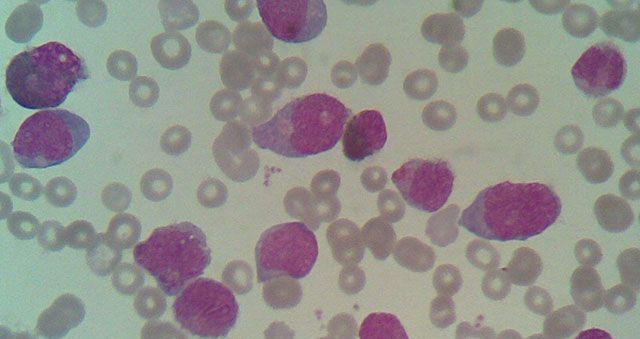
核心结合因子相关急性髓系白血病(CBF-AML)严重么？

-

试管移植后第十天孕试纸验孕不用晨尿会影响结果吗?
今天是试管移植第十天,我下午的时候感觉有点嗜睡,婆婆说可能是怀上了,让我赶紧测一下,我就买了孕试纸回来测,只有一条杠,我看说明书上说要用晨尿,但是我这是中午测的..
2023-04-07 10:04 -
在东北人工授精费用各家医院花费均有差异!整理沈阳区表一览
随着人工授精技术在国内的普及和发展,在沈阳做人工授精的成功率也高了起来,而沈阳人工授精的费用也成为了当地不孕不育家庭比较关注的地方,其实在沈阳做人工授精并不贵,..
2023-04-21 09:58 -

中国有精子库吗?国内各个省份精子库汇总
不止国外设立有精子库,我国大多数省份也都设立了精子库,中信湘雅人类精子库就是中国最早的人类冷冻精子库,它创建于1981年,是目前国内规模最大,技术力量最雄厚的人类精..
2023-05-01 09:46 -

泰国诺菲梵(LaVida):试管成功率高、医生团队阵容强大
泰国医疗费用低、试管婴儿成功率高是多数人选择这里的原因,确实泰国辅助生殖行业近几年来也发展的飞速,特别还涌现了一批知名的辅助生殖医疗机构,今天这里本文介绍到的诺..
2023-05-03 10:00 -
核心结合因子相关急性髓系白血病(CBF-AML)严重么?
核心结合因子相关急性髓系白血病(CBF-AML)是一种急性髓系白血病。在正常骨髓,早期血细胞造血干细胞发育成血细胞的几种类型:保护身体免受感染的白血细胞,携带氧气的红血..
2023-05-05 09:23 -
柬埔寨试管婴儿攻略-流程和柬埔寨试管婴儿医院的要求
为方便前往柬埔寨做试管婴儿的客户出行规划与行程安排,围绕柬埔寨试管婴儿流程和柬埔寨试管婴儿医院的要求,特整理柬埔寨试管婴儿攻略,旨在帮助更多人在海外试管婴儿期间..
2023-05-05 10:06 -

怎么看PCR基因变异报告,解读高通量测序染色体检查
遗传学检查通常分为分染色体水平和基因水平的检测。再再次强调临床上绒毛取样,羊水或脐血穿刺实际上都是指获取胎儿样本的手段而非检测方法。获取胎儿样本后根据不同的临床..
2023-05-05 10:18 -

54岁可以做试管婴儿吗?绝经都有怀孕的希望
看过了不少50、60多岁高龄还能通过试管婴儿怀孕后,很多大龄女性对自己再生育也是充满的信心,虽然说即便绝经也能有怀孕的希望,但是高龄妊娠的风险并不会转移,确定做试管..
2023-05-20 08:43 -

想学53岁周慧敏冷冻卵子?打算冻卵的女性应考虑这些事
被大家称为不老女神的周慧敏,早前也传出了“冷冻卵子”的新闻,确实1967年出生的她现在算下来已经50多岁了,可能冻卵亦成为了一个良方。53岁周慧敏冻卵53岁周慧敏坦言早于..
2023-05-20 09:23 -
什么是宫冷不孕?女性不孕要去医院怎么检查?要检查哪方面?
32岁,想要孩子一直没有怀上,这两年来因为上班压力山大,常常熬夜加班,身体也变差了好多,月事来时常常是手脚冰凉、头晕头痛、还会痛经、有血块、月事量也是偏少的,朋友..
2023-05-23 09:14 -
天津做人工授精贵吗?主要包含这4部分的费用
天津市一个物价水平不算高的城市,所以很多人认为天津人工授精的费用也很便宜,事实上在天津做人授的费用偏不便宜还是取决于每个家庭的实际情况,今天我们就一起来看看天津..
2023-05-24 10:08 -

昆明主城区落户限制取消,材料齐全宝宝轻松上户口
近日,云南省委、省政府印发关于建立城乡融合发展意见,其中就明确要全面放开全省城镇地区户口迁移政策,取消昆明市主城区落户限制,建议以经常居住地登记户口的政策措施,..
2023-05-25 08:26 -

高龄试管婴儿怀孕风险高,那A卵B怀靠谱吗?
42岁,一直没有孩子,期间流产多次,每次都是在3个月左右就流产,查过染色体没有问题,现在内膜一直只有6左右,期间尝试各种调理都没法提升内膜,我不想等下去了,能找妹妹..
2023-05-28 09:55 -

学饮杯能喝奶粉吗?具体定论有经验的宝妈们说了才算
学饮杯这款产品在我们日常生活中较为常见,一些宝妈们会用到该产品给自家宝宝练习喝水,但很多宝宝都不爱喝水,因此一些宝妈想让宝宝在喝奶粉与喝水之间转换,因此经常听到..
2023-06-11 10:06 -

什么条件可以移植鲜胚?要求内膜条件过关其一
就目前来看的话在试管婴儿移植环节采用鲜胚移植的人不在少数,因为能够大大缩短治疗周期时间的缘故也有很多女性会选择鲜胚移植,但你知道吗?并不是所有人都适合进行鲜胚移..
2023-06-17 09:45 -

首次检查糖类抗原125偏高别担心搞清原因很重要
糖类抗原125偏高常见于卵巢癌,并不是一旦出现糖类抗原125偏高就肯定是患有卵巢癌,一些非恶性肿瘤、胸腹水、羊水、早期妊娠、盆腔炎、阴道炎等情况也有可能会引起糖类抗原..
2023-06-22 08:33 -

2022年必定怀孕生女孩的月份是几月?
我们家老大是个男孩,想再给他生个妹妹,但是又担心再生个儿子,到时候负担比较大,所以就一直在纠结要不要备孕, 后来听有姐妹说在某些月份怀孕的话必定生女孩,所以想知..
2023-06-27 09:29 -

男性弱精症生精片吃多久能有效果?
我和老婆结婚多年都没有怀孕,在医院检查我有少精弱精的问题,因此我们选择了做试管,为了提高精子数量医生给开了生精片吃着,一天三次,一次四片,吃了已经半个月左右了,..
2023-06-30 09:06 -

巴厘岛皇家试管婴儿须知:机场到医院最佳路线推荐
提到巴厘岛皇家试管婴儿医院,大家第一反应就是这家医院在巴厘岛,然而对于具体位置及路线并不清楚,通过百度也并不一定能够搜索到,更别说其它地图了,这里将会给大家普及..
2023-07-02 09:50 -

盘点影响泰国试管婴儿受精卵着床的3大元凶,第一很常见
备孕失败没有任何症状,可能会存在着床失败流血会留几天这样的疑问,其实只是因为身体内激素的变化,而因为体质的不相同,所以并非所有患者会出现排卵后着床不成功症状,那..
2023-07-07 09:02
微信分享
扫描二维码分享到微信或朋友圈